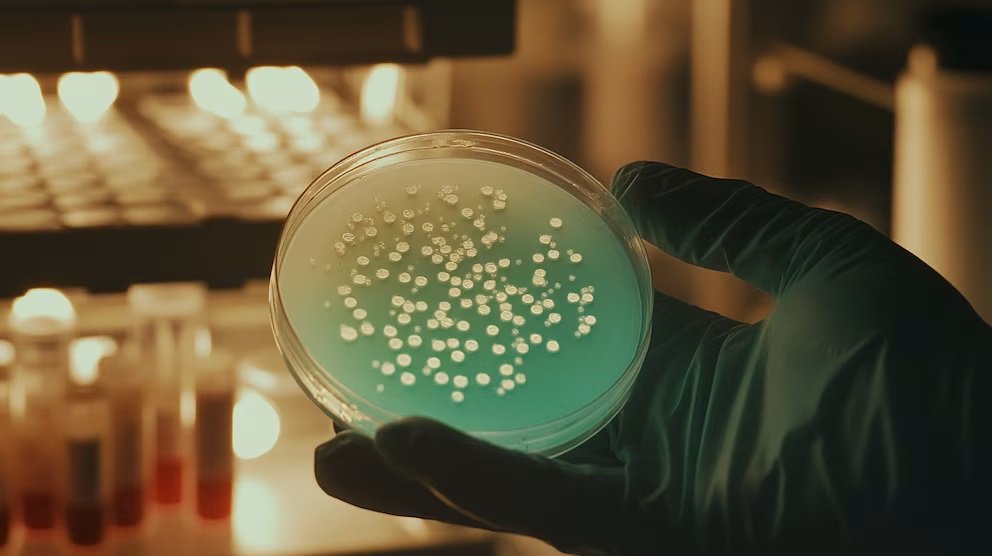

ciencia
Científicos detallan cuándo surgió el beso
Según los expertos, esta manera de expresar afecto ya ocurría hace alrededor de 21 millones de años, cuando todavía la humanidad no existía.
La investigación sobre el origen del beso humano adquirió en las últimas horas una nueva dimensión gracias a un análisis dirigido por la Universidad de Oxford, que sitúa este comportamiento en el ancestro común de los grandes simios hace alrededor de 21 millones de años. El estudio refuerza además la hipótesis de que los neandertales también participaron en esta forma de contacto social. De esta manera, indicaron que antes de cualquier palabra escrita, el beso ya habría formado parte de los encuentros entre neandertales y personas modernas en Eurasia. Bajo este contexto, aseguraron que este gesto nació millones de años antes, cuando todavía no existía la humanidad tal como se la conoce en la actualidad.
Para los científicos, besar no siempre tiene que ver con el amor. Se propusieron comprender si besar tenía ventajas biológicas, ayudaba a crear lazos sociales o cumplía otras funciones esenciales. Consideraron que el beso es una acción amistosa o afectiva entre miembros de la misma especie, con contacto boca a boca, movimiento de labios y sin intercambio de alimento. Esta definición excluyó prácticas como dar comida masticada de boca a boca. El objetivo de los investigadores fue saber si besar se inventó varias veces en la evolución o si fue una herencia de ancestros comunes de humanos, neandertales y grandes simios. Para responder a esas preguntas, el estudio revisó investigaciones previas, videos y reportes sobre primates africanos y asiáticos. Además, sumó datos genéticos sobre bacterias presentes en la boca de humanos y neandertales.
Los especialistas subrayaron que se trata de una conducta con riesgos evidentes, especialmente la transmisión de enfermedades, pero que aún así se conservó en distintas especies de simios de gran tamaño. Las simulaciones, ejecutadas millones de veces, revelaron que el ancestro de los grandes simios entre 21,5 y 16,9 millones de años atrás probablemente ya utilizaba esta forma de contacto como parte de su comportamiento social. La autora principal del estudio, Matilda Brindle, destacó que “esta es la primera ocasión en la que se adopta una perspectiva evolutiva tan amplia para examinar el beso”.
De igual manera, el equipo consideró que se necesitan más investigaciones que recopilen datos más detallados y comparen distintas formas de besar en animales y en personas de diferentes culturas, ya que por ejemplo, no pudieron saber cuán frecuente es el beso, ni diferenciar claramente entre los distintos tipos de besos.
Humanos y neandertales
El análisis también es consistente con trabajos previos que documentan la transferencia de microbios orales y la mezcla genética entre humanos y neandertales. Estas evidencias elevan la probabilidad de que ambas especies compartieran el beso como una forma de interacción social relevante en su relación. El coautor Stuart West remarcó también que comprender comportamientos que no dejan huella fósil requiere integrar datos conductuales y herramientas evolutivas, mientras que la investigadora Catherine Talbot añadió que el beso solo está registrado en torno al 46% de las culturas humanas actuales. Este dato, según indicó, mantiene abierto el debate sobre si se trata de una conducta heredada o de una invención cultural transmitida entre generaciones. Vale recordar, que durante mucho tiempo, se pensó que neandertales y humanos modernos no tenían contacto o apenas coincidían en territorio, ya que se creía que pertenecían a linajes separados sin mayor interacción.